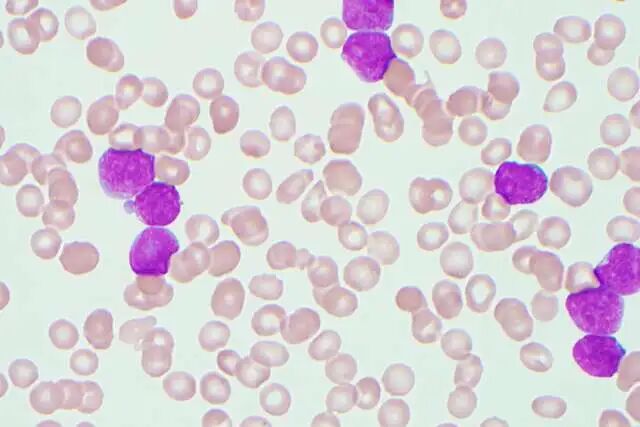

02/11/2026
在 UCLA Health,癌症治疗的每一次突破,都源自对医学未来的长期探索。医生们不仅在治疗疾病,更在不断重塑人类理解癌症、并最终战胜癌症的方式。而这些来自实验室的科研成果,正切切实实地改变着全球患者的命运。
Dennis Slamon 博士的研究,正是这一精神的最佳写照。早在”精准医疗”尚未成为共识之前,他便率先锁定 HER2 基因这一关键靶点,推动了赫赛汀(Herceptin)的诞生。由 UCLA 牵头的临床试验于 1990 年启动,1998 年获得 FDA 批准。至今,这一疗法已惠及近 350 万名女性,使相关乳腺癌患者的生存率提高了 50% 以上。
2025 年,Slamon 博士因此当选美国国家发明家科学院院士。

这并非偶然。仅在 2025 年,UCLA 就有 30 余位学者入选全球”高被引科学家*”,跻身全球学术影响力前 0.1%。
本文将带您回顾 UCLA Health 在精准治疗、免疫疗法与诊断技术领域的最新突破——让抗癌不止于延长生命,更通向高质量生活。
在 UCLA Health,卓越的癌症治疗始终由两个核心驱动:前沿的科学突破,以及被科学赋予意义的真实生命个体。
对患者而言,康复从来不只是数据上的胜利,更是对自我身份的守护——那些让人感觉”依然活得像自己”的瞬间,才是真正的治愈。

保罗·亨德里克斯(Paul Hendrix)是一位一生追逐海浪的环球冲浪者。然而,一纸”EGFR 阳性肺腺癌”的诊断,几乎让他与大海告别。
按照传统方案,他需要切除部分肺叶,这意味着肺活量将大幅下降。对一名冲浪者而言,呼吸能力的丧失,等同于失去人生最重要的部分。
保罗希望找到一种方案:既能有效控制癌症,又不会剥夺他热爱的生活方式。
在 UCLA Health 多学科专家团队的综合评估下,他选择了 SBRT(立体定向放射治疗)。这是一种高度精准、影像引导的放疗技术,能够在最大程度保护健康组织的前提下,精准打击肿瘤,尤其适用于会随呼吸移动的肺部器官。
整个治疗过程高效而温和:三次门诊,每次不到 10 分钟,几乎没有明显副作用。
几天后,他骑上了心爱的摩托车;几周后,他重新站在了冲浪板上。
保罗的故事,正是 UCLA Health 医疗理念的缩影——不仅为生存而战,更守护每个人所热爱的生活。
在 UCLA Health,我们深知:抗癌的第一步,是精准诊断。
2025 年,我们在多项诊断技术上取得突破,力求在疾病尚未全面暴露之前,便将其精准捕获。

为提升前列腺癌的诊断与治疗精度,UCLA 研究人员开发了 Unfold AI。
这项技术可将传统 MRI 影像升级为高度精细的”肿瘤地图”,为医生提供更清晰的决策依据。
在一项研究中,面对极易被忽视的”精囊受累”情况,传统 MRI 的检出率仅为 52%,而 Unfold AI 的检出率高达 92%。
有了这张”高清导航图”,医生得以避开盲区,直达病灶。

对于转移性乳腺癌患者而言,持续、动态的病情监测至关重要。
UCLA 最新研究显示,通过检测血液中的循环肿瘤 DNA(ctDNA),医生可以更早判断疾病走向。
如果 ctDNA 检测结果为阴性,通常预示着更长的无进展生存期——让治疗不再只是”被动应对”,而是”提前布局”。
在 UCLA Health,癌症治疗的飞跃离不开对科研的持续投入。
我们坚信,癌症治疗的未来属于精准医学——治疗不再是千篇一律的模板,而是基于疾病生物学特征的个性化定制。

在肺癌手术中,彻底清除肿瘤与”留下隐患”之间,可能只差几个肉眼无法察觉的细胞。
过去,医生必须等待术后病理报告,患者往往需要在麻醉状态下多等待 30 分钟甚至更久。
如今,UCLA Health 正在研发一种类似”笔”的新型设备,可在手术中进行实时细胞分析,仅需数秒即可提供判断依据。
这使手术真正做到:多一分则伤,少一分则险,最大限度保留健康肺组织。
对于像保罗这样的运动爱好者而言,这意味着术后依然能拥有强大的耐力与呼吸能力。
2025 年,UCLA Health 的科研团队在一种长期被认为”难以攻克”的侵袭性白血病机制上取得突破。
研究人员发现了一种全新的化合物,能够精准干扰为急性白血病提供能量的关键蛋白质。
这一策略如同切断敌军的补给线,不仅抑制癌细胞生长、诱导其死亡,还能从源头减少”白血病起始细胞”,显著降低复发风险。

1. 低级别胶质瘤的首款靶向药
由 UCLA 牵头并参与的临床研究,推动了新药 Vorasidenib 的获批。这是全球首个针对 IDH1/IDH2 基因突变脑胶质瘤的靶向药物。
该药可使患者的病情稳定时间延长至原来的两倍以上,更重要的是,为患者赢得宝贵的”无化疗时间”,从而减少记忆力减退等长期副作用。
2. 个性化疫苗的”强心针”
UCLA 研究人员发现,将树突状细胞疫苗与免疫增强剂联合使用,可显著提升机体对抗恶性胶质瘤的能力,如同为免疫系统注入一剂强心针。

UCLA Health 的研究团队利用捐献的造血干细胞,成功批量培养出增强版 CAR-NKT 细胞,实现常备存储、即时使用。
相较传统个性化疗法,这一方式在保障治疗时效的同时,大幅降低成本。
在三阴性乳腺癌研究中,团队通过多重识别机制,同时攻击多个肿瘤标志物,形成”多点合围”,有效防止肿瘤通过单一标志物改变而逃逸。
2026 年 1 月 1 日,UCLA Health 正式成立核医学与诊疗一体化系(Nuclear Medicine & Theranostics),成为全美首个独立成系的此类部门。
这一模式致力于缩短从”实验室”到”病房”的距离。通过放射性药物,实现”发现即治疗”——既能精准定位疾病,又能直接实施靶向打击,为复杂与疑难疾病带来新的希望。

UCLA Health 的癌症照护项目,始终致力于将高科技医学与高关怀度照护相结合。从治疗前到治疗后,从患者到家庭,从康复期到幸存期,支持从不间断。
因为我们深知:
尽管科研不断取得突破,癌症仍可能在身体、情感与社会层面改变一个人与世界的关系。
真正全面的癌症照护,必须关注”完整的人”,而不仅是疾病本身。
02/11/2026